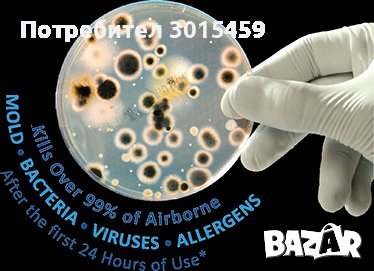

Nicole
В Bazar.BG от 18 март 2021г.
Последно активен
вчера в 22:35 ч.
Дезинфекция в климатичните системи mini UV LED, Fresh Aire UV → Обява 35342853
Дезинфекция в климатичните системи mini UV LED, Fresh Aire UV
Състояние
Ново
Доставка
Лично предаване; Купувача
Fresh Aire UV / mini UV LED за сплитове, конвектори и трудно достъпни места.
Mini-split климатични системите стават все по-популярни в целия свят. За съжаление те, както и всички климатични системи са склонни към вътрешен растеж на плесен. Ръстът на мухъл съкращава ефективността на турбината на климатичната система и може да бъде сериозен риск за здравето Ви. В допълнение, въздушната система разпространява голямо разнообразие от биологични замърсители във въздуха, като микроби, вируси, полени и алергени.
Доказано ефективен при стерилизиране на плесен и други биологични замърсители. Мухълът и бактериите се разрастват в топлообменника и дренажната тръба на климатика и се разпространяват чрез вентилирането.
Мухълът съкращава живота на Вашият климатик и губи енергия чрез намаляване на ефективността му.
mini UV LED на Frеsh Aire UV убива мухъла и ще намали необходимостта от поддръжка на системата. Поддържа чиста мини-сплит системата, без мухъл и микробен растеж
• Спестява енергия / намалява разходите за поддръжка
• Удължава живота на mini-split системата
• Подобрява качеството на въздуха в помещенията
Гаранция: 5 години
Цена за 1 брой: 250 лв.
Цена за 2 броя и над: 190 лв. бройката!
Преглеждания: 495
Другите търсят също
Категории:
Перални
Сушилни
Хладилници
Фризери
Бойлери
Съдомиялни
Печки, фурни
Абсорбатори
Котлони
Микровълнови
Кафемашини
Кани
Скари
Тостери
Гофретници
Фритюрници
Кухненски роботи
Хлебопекарни
Мултикукъри
Миксери
Сокоизстисквачки и цитрус преси
Блендери
Чопъри и пасатори
Месомелачки
Уреди за готвене на пара
Електронни везни
Чушкопеци
Прахосмукачки
Ютии
Шевни машини
Парочистачки и Водоструйки
Климатици
Отоплителни печки
Камини
Радиатори
Влагоабсорбатори и влагоуловители
Вентилатори
Други
Ремонт на бяла и черна техника
Вход
Регистрация
Влез в профила си или се регистрирай, за да не губиш наблюдаваните обяви, търсенията си и следваните потребители – ще ги имаш навсякъде с теб.
Вход/Регистрация